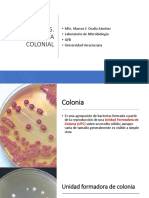

0% encontró este documento útil (0 votos)
2K vistas2 páginasEsporas o Conidios
Este documento define y describe diferentes tipos de esporas producidas por hongos. Algunos ejemplos son esporangiosporas que se producen dentro de un esporangio, conidios que se forman en el extremo de una hifa, macroconidios y microconidios que varían en tamaño, y basidiosporas y ascosporas que son esporas sexuales.
Cargado por
Jonathan CastroDerechos de autor
© Attribution Non-Commercial (BY-NC)
Nos tomamos en serio los derechos de los contenidos. Si sospechas que se trata de tu contenido, reclámalo aquí.
Formatos disponibles
Descarga como DOCX, PDF, TXT o lee en línea desde Scribd
0% encontró este documento útil (0 votos)
2K vistas2 páginasEsporas o Conidios
Este documento define y describe diferentes tipos de esporas producidas por hongos. Algunos ejemplos son esporangiosporas que se producen dentro de un esporangio, conidios que se forman en el extremo de una hifa, macroconidios y microconidios que varían en tamaño, y basidiosporas y ascosporas que son esporas sexuales.
Cargado por
Jonathan CastroDerechos de autor
© Attribution Non-Commercial (BY-NC)
Nos tomamos en serio los derechos de los contenidos. Si sospechas que se trata de tu contenido, reclámalo aquí.
Formatos disponibles
Descarga como DOCX, PDF, TXT o lee en línea desde Scribd